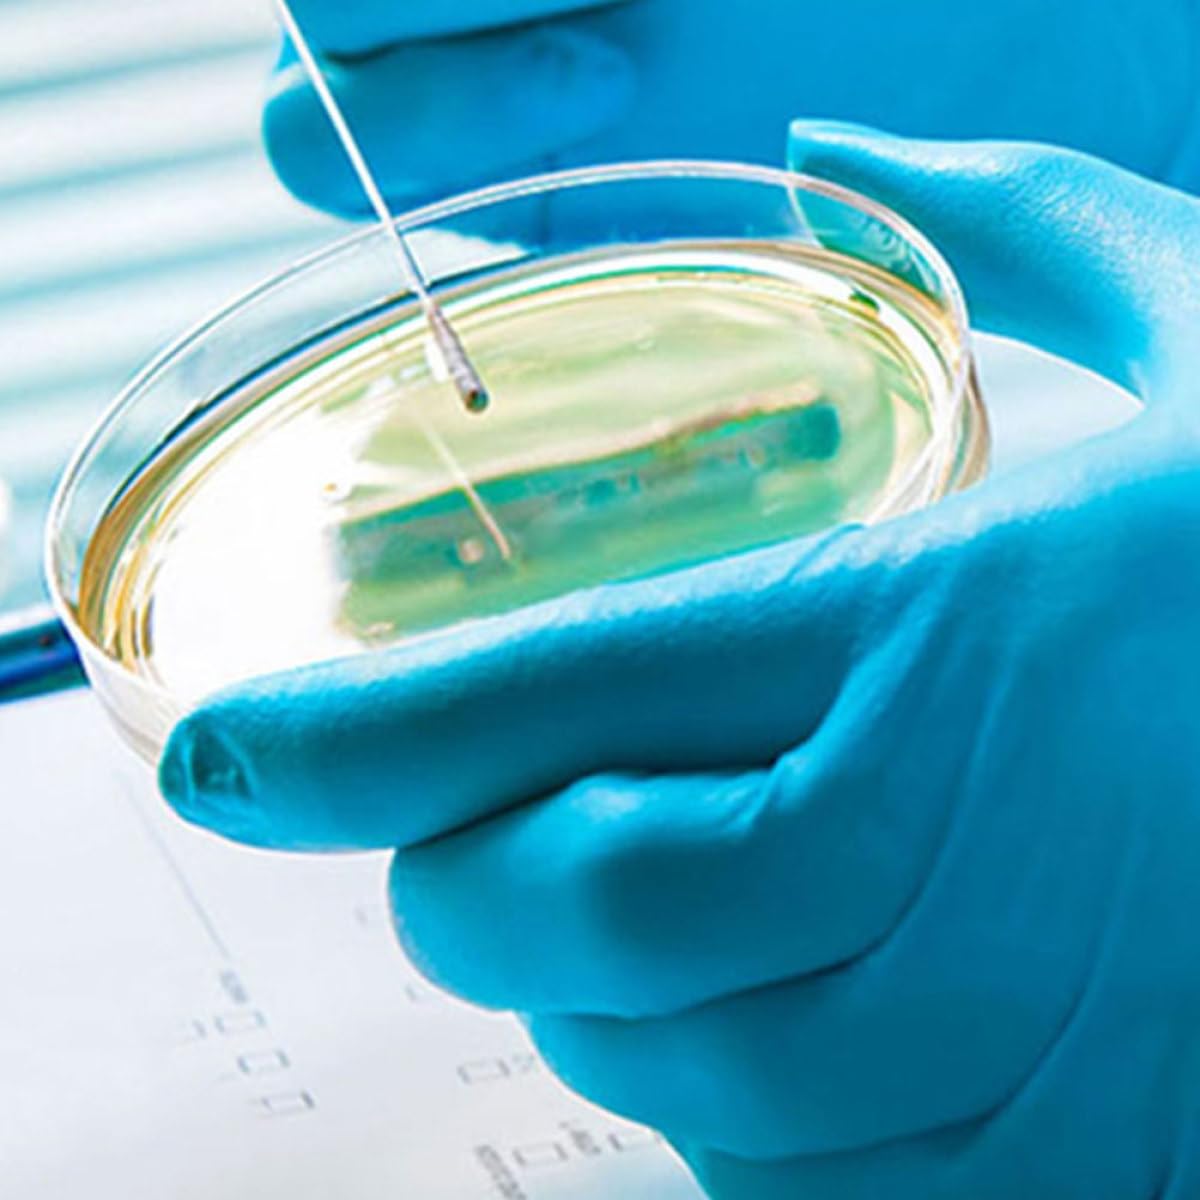
10 x 100mm Clear Laboratory Petri Dish Lids Sterile Culture Containers for Scientific Analysis and Lab Experiments

10 x 100mm Clear Laboratory Petri Dish Lids Sterile Culture Containers for Scientific Analysis and Lab Experiments
Product details
| Management number | 211014068 | Release Date | 2026/04/04 | List Price | $36.00 | Model Number | 211014068 | ||
|---|---|---|---|---|---|---|---|---|---|
| Category | |||||||||
Package List 10 Petri dishes with lids Features - Colour: transparent. Product information: Plastic Petri dish - Dimensions: 10 x 10 x 1 cm / 3.93 x 3.93 x 0.39 inches. - Material: Plastic - Thanks to their transparent colour and smooth surface, the Petri dishes guarantee the safety of the samples. - Small and lightweight, so it can be carried with you anytime and anywhere, such as petri dishes for equipment. Made of high strength material, this Petri dish is heat resistant and will not crack or break easily. - Professional tools for chemistry experiments, these Petri dishes facilitate the transfer of experiments. - With its lid, this Petri dish protects the samples and easily meets the different needs of specimen containers. Product Description Petri dishes for crops. Widely used for education, chemistry, research and various applications. Laboratory Petri Dishes. Enough quantity for easy use and replacement. Petri dishes for chemistry. Ideal for use at home or laboratory Our Petri dishes are suitable for students for their experiments and are also perfect for scientific research.
- Petri dish — transparent and smooth surface, petri dish ensures the safety of samples. laboratory petri dish
- Petri dishes – for large-scale experiments, their size is more convenient, providing a solution for scientists
- Lab Cell Culture Box - Made from durable materials for extended use, ensuring its resistance to repeated use without breaking or wearing
- Culture Petri Dish - Made of high strength material, this petri dish is heat resistant and not easy to crack or break
- Transparent petri dish for scientific laboratory - with lid, this petri dish protects the samples and easily meets different needs. cell culture plate with lid
| Item Weight | 6.7 ounces |
|---|---|
| Manufacturer | KHBUAB |
| Item model number | F532TQ57K00V |
| Product Dimensions | 3.94 x 3.94 x 0.39 inches |
Correction of product information
If you notice any omissions or errors in the product information on this page, please use the correction request form below.
Correction Request Form